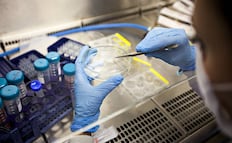
Trasplante de células madre logra curación de VIH; es el resultado de más de una década de investigación internacional

[Publicidad]
Principales

Reportan, ahora, desaparición del alcalde de Taxco; ocurre tras privación de la libertad de su padre
Juan Andrés Vega Carranza fue privado de la libertad cuando buscaba rescatar a su padre, director del IMSS-Bienestar; fuerzas federales y estatales ya lo buscan en Guerrero y estados vecinos
Paro en el Metro CDMX hoy 13 de abril; sindicato retoma protestas, sigue las actualizaciones aquí
Tras la tregua del fin de semana, trabajadores reanudan el ausentismo y rechazo a horas extra; el STC pide anticipar traslados ante posibles retrasos y saturación
Prevén que kilo de tortilla suba hasta 4 pesos por aumento de harina de maíz; competencia desleal distorsiona mercado, acusan
Una de las grandes desventajas para las tortillerías está en la competencia desleal, en tortillerías informales que no pagan impuestos
Nación

Sheinbaum: Becas son para que estudiantes tengan "lo mínimo indispensable"; hay "mucha responsabilidad" en los jóvenes, dice
La Mandataria federal reiteró que la obligación del gobierno es que la educación pública sea la mejor

Acusado de fraude al Infonavit es detenido por el ICE; Rafael Zaga Tawil cuenta con orden de aprehensión en México
En julio de 2024, un juez federal del penal de Almoloya de Juárez amplió y reiteró las órdenes de aprehensión contra Rafael Zaga Tawil y su hijo, Elías Zaga Hanono
Precio de la gasolina: Profeco retoma campaña para quienes “se vuelan la barda”; con lonas exhibe a gasolineras
“El precio de la magna no puede pasar de 24 pesos”, dijo la Presidenta
[Publicidad]
Podcast y Transmisiones

Reuniones FMI y BM, un podcast de Ana Paula Ordorica

Tras diálogo, EU e Irán no llegan a un acuerdo

¿Qué Plan?

Peso x Peso

El ICE y la cacería de migrantes de Trump; una charla con Claudio Ochoa

Convocan al Tercer Premio Nacional de Periodismo en Salud; buscan reconocer difusión y comprensión
San Luis Potosí
La leyenda de "El Ermitaño" que habitó la Cañada del Lobo de SLP
Puebla
De cuánto es la fortuna de Socorro Romero, por la que se pelea familia en Puebla
Oaxaca
¿Con qué chile se prepara el mole negro? Famoso platillo de Oaxaca
Edomex
Muere Henry, el niño de 2 años víctima del ataque con bombas molotov a tiendas 3B en Valle de Chalco
[Publicidad]
Periodismo de Investigación
Estados y Metrópoli

Muere Henry, el niño que fue herido en incendio de una tienda en Valle de Chalco; sufrió quemaduras en el 80% de su cuerpo
La Fiscalía del Estado de México informó que solicitará al juez la reclasificación de la acusación contra los cuatro detenidos por los hechos

Reportan derrame en la refinería de Pemex en Deer Park; ocurre en canal de navegación de Houston
Autoridades ya trabajan en la contención, no se prevén cierres de tránsito
Secuestran a director del Hospital General de Taxco; también es padre del alcalde
Fuentes del hospital informaron que Juan Vega Arredondo no se presentó a sus actividades programadas ayer sábado 11 de abril
Mundo y Cartera

Juez desestima demanda de Trump contra el Wall Street Journal por caso Epstein; volverán a presentar la demanda
El mandatario exige 10 mil millones de dólares y acusa al medio de "difamación".

Acusado de fraude al Infonavit es detenido por el ICE; Rafael Zaga Tawil cuenta con orden de aprehensión en México
En julio de 2024, un juez federal del penal de Almoloya de Juárez amplió y reiteró las órdenes de aprehensión contra Rafael Zaga Tawil y su hijo, Elías Zaga Hanono
Trump pide McDonald's desde la Casa Blanca; le da 100 dólares de propina a la repartidora
Es parte de una campaña para eliminar los impuestos sobre esos ingresos
[Publicidad]
Espectáculos y Cultura

Carta alerta que la fusión de Warner y Paramount dañaría la industria: Joaquin Phoenix y Bryan Cranston, entre los firmantes
Han observado "un fuerte descenso en el número de películas producidas y estrenadas"

Ed Sheeran anuncia concierto en la CDMX, ¿qué sabemos?
El cantante compartió la noticia en sus redes y sus fans reaccionan expectantes
Ruby Rose acusa a Katy Perry de agresión sexual; el representante de la cantante lo niega
La actriz alega que eran amigas hace dos décadas, cuando habrían tenido lugar los acontecimientos
Deportes

Gonzalo Piovi y la fe celeste; Cruz Azul va por una noche histórica ante LAFC
El defensa central argentino confía en que La Máquina será capaz de remontar ante el conjunto angelino y clasificará a semifinales de Concachampions

Cruz Azul cree en la remontada y Nicolás Larcamón exige el partido perfecto para conseguirla
La Máquina tiene un reto mayúsculo al enfrentar a Los Angeles FC en la vuelta de los cuartos de final de la Copa de Campeones de la Concacaf
Liga MX: ¿Cómo se jugaría la Liguilla del Clausura 2026 si hoy finalizara la Fase Regular?
Todavía faltan tres jornadas por disputarse, pero estos serían ahorita los duelos de los cuartos de final de la Fiesta Grande
Hidalgo
Denuncian presunta contaminación de presa de San Antonio Regla en Huasca
San Luis Potosí
"Sería incongruente estar ahora a favor del fracking": Diputada morenista
Querétaro
Sondeo: Sortean queretanos aumento de precios en los productos
Puebla
VIDEO Trailero se salva de asalto en la autopista Puebla-Córdoba
Lo mejor de Suplementos
Tendencias

Día Internacional del Beso 2026: ¿por qué se festeja el 13 de abril y cuál es su curioso origen?; esto se sabe
El beso concentra emociones como afecto, deseo, consuelo y respeto

Verástegui lanza dardo a Trump tras calificar al Papa León XIV de “débil”; “la iglesia no existe para agradar a los gobiernos”
El republicano criticó al pontífice por temas internacionales y generó controversia tras difundir imagen con IA
VIDEO: astronauta de Artemis II Christina Koch comparte reencuentro con su perrita; reacción de la mascota se viraliza
El tierno momento entre la astronauta y su perrita ha sido aplaudido por millones de usuarios, quienes celebran el amor a las mascotas
Por si no lo viste

Tabasco, el desencanto del “Dubai mexicano”
Un sector servicios en abandono y decadencia El impago a Pemex a proveedores ha repercutido en la entidad de forma negativa: Canacintra

En tres años abandonan a 14 bebés en el Edomex; existencia humana se cosifica: expertos
El problema persiste pese a las acciones implementadas: DIFEM; los hijos se han vuelto un objeto y su existencia ha sido cosificada, opinan expertos
"¡Buenos días, mundo!"; NASA comparte las primeras imágenes de la Tierra tomadas por Artemis II
"Tenemos nuevas y espectaculares imágenes de alta resolución de nuestro planeta natal", destaca la agencia espacial estadounidense